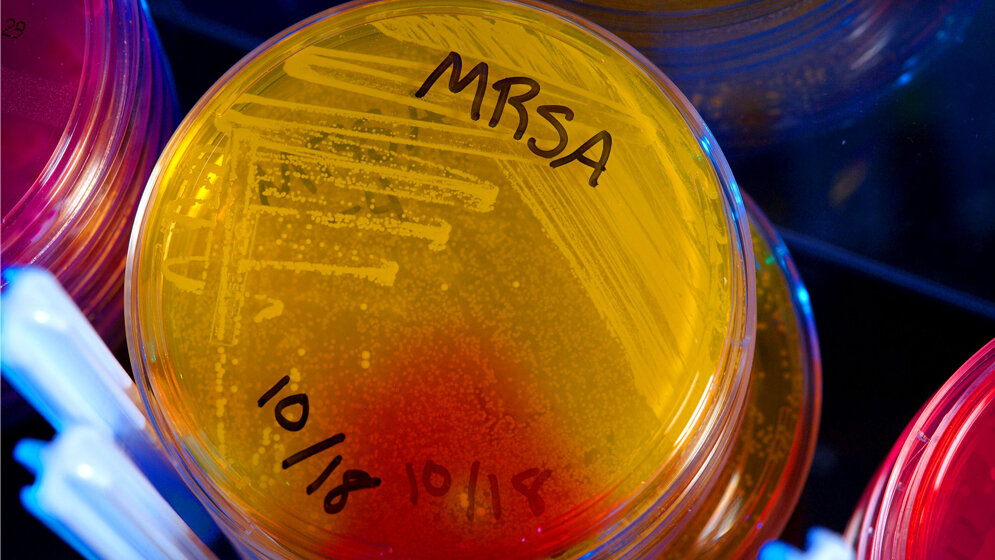
In dieser Petrischale wachsen MRSA-Keime.

Ein neues Forschungsprojekt der Martin-Luther-Universität Halle-Wittenberg (MLU), der Universität Greifswald und der Universität Würzburg entwickelt neue Wirkstoffe im Kampf gegen resistente Bakterien. Das Bundesministerium für Bildung und Forschung (BMBF) fördert das Vorhaben bis Ende 2019 mit rund einer Million Euro. Im Zentrum des neuen Forschungsprojekts steht ein spezielles Enzym in Bakterien, die sogenannte Pyruvatkinase. Das Enzym ist für den Stoffwechsel von zentraler Bedeutung. Die Idee der Forscher: Lässt sich dieses Enzym ausschalten, behindert das den Stoffwechsel der Bakterien - und macht sie letztlich unschädlich. „Bisher gibt es keine Antibiotika, die direkt auf die Pyruvatkinase abzielen. Das macht sie für die Erforschung und Erprobung neuer Wirkstoffe interessant, denn somit können auch bestehende Antibiotikaresistenzen gebrochen werden“, sagt Prof. Dr. Andreas Hilgeroth vom Institut für Pharmazie der MLU.
Suche nach besonders markanten Strukturabschnitten
Im Rahmen ihres Projekts wollen die Forschergruppen deshalb klären, wie solche neuartigen Substanzen aufgebaut sein müssen, um ihre Wirkung ideal entfalten zu können. Dafür erforschen sie die Struktur der Pyruvatkinase und suchen nach besonders markanten Strukturabschnitten, die es weder in anderen Bakterien noch im menschlichen Körper noch einmal gibt. Für diese Struktur entwickeln sie dann Substanzen, die nur an einer speziellen Stelle andocken können und so möglichst wenige Nebenwirkungen haben. „Das Ganze kann man sich wie einen Schlüssel vorstellen, der nur in ein bestimmtes Schloss passt. Diese Schlüssel entwickeln wir hier in Halle“, so Hilgeroth weiter.
Substanzen auf unerwünschte Nebenwirkungen überprüfen
An der Julius-Maximilians-Universität Würzburg überprüfen Infektionsbiologen um PD Dr. Knut Ohlsen dann die neuen Substanzen auf ihre antimikrobiellen und toxischen Eigenschaften. Speziell geht es hier darum, die Substanzen auf unerwünschte Nebenwirkungen überprüfen. Also ob sie tatsächlich nur die gewünschten Strukturen innerhalb der Bakterien angreifen und nicht etwa menschliche Zellen. Die Wirksamkeit der neuen potenziellen Wirkstoffe und die Auswirkungen auf den Stoffwechsel der Bakterien werden an der Universität Greifswald erforscht. Hier leitet Prof. Dr. Michael Lalk vom Institut für Biochemie die Forschungsarbeiten, die aufzeigen sollen, wie der Stoffwechsel der Bakterien beeinflusst wird. Am Ende stehen im Idealfall mehrere Kandidaten für neue Wirkstoffe gegen bakterielle Erreger, wie Staphylokokken oder die besonders in Krankenhäusern gefürchteten MRSA-Keime. „Unser Ziel ist es, eine neue Zielstruktur für den Kampf gegen resistente bakterielle Erreger zu etablieren. So lassen sich womöglich einfachere, günstig verfügbare Wirkstoffe entwickeln“, fasst Hilgeroth zusammen. Zwar könnten Bakterien auch gegen diese Wirkstoffe Resistenzen entwickeln. Da hier aber ein völlig neuer Ansatz verfolgt wird, dürfte dies längere Zeit dauern.
Förderung des Projektes
Das Verbundprojekt der Universitäten Halle, Würzburg und Greifswald wird im Rahmen der BMBF-Förderrichtlinie „Targetvalidierung für pharmazeutische Wirkstoffentwicklung“ gefördert. Die Erkenntnisse aus dem Forschungsprojekt sollen möglichst rasch in eine konkrete Anwendung überführt werden. Deshalb orientieren sich die Forscher bereits in der Anfangsphase an industriellen Standards und suchen auch den Kontakt zur Pharmaindustrie.
Quelle: idw/Martin-Luther-Universität Halle-Wittenberg
Artikel teilen